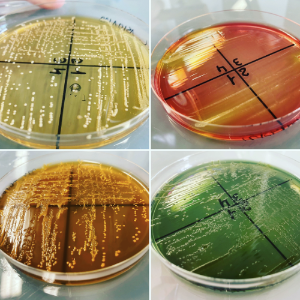
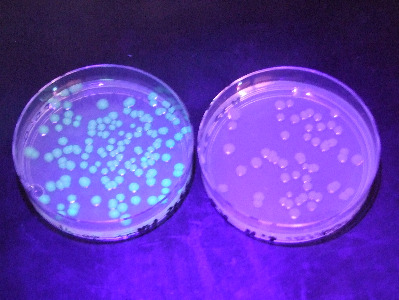

Et pourquoi pas une série STL Biotechnologie après la seconde ?
Une série résolument scientifique.

La série STL est une série résolument scientifique et exigeante et dont l'approche des concepts se fait via l'expérimentation au laboratoire et la démarche expérimentale.
Un travail de la biologie à différentes échelles.


Travail en laboratoire

Travail au poste de microbiologie

Préparation d'une gélose

Etuve pour la culture des microrganismes
Milieux de culture
Culture de bactéries fluorescentes

Penicillium roqueforti

Microscopie

Bactéries (x1000)

Un indispensable du labo : la pipette

Prélèvement d'un réactif

Dépôt sur gel d'électrophorèse

Dosage volumétrique

Dosage spectrophotométrique

Pesée à la balance de précision
EXEMPLES de poursuites d'étude après un bac STL Biotechnologie
-
Divers BTS de Biologie appliquée (Bac+2) → biologie médicale, recherche et production, cosmétique, eau et environnement, agrolimentaire...
-
DTS IMRT (Bac+3) → paramédical
-
BUT Génie Biologique (Bac+3) → agronomie, biologie médicale, sciences de l'aliment, sciences de l'environnement
-
Classe préparatoire TB puis grande école (Bac+5)
-
Parcours Licence (Bac+3) Master (Bac+5) Doctorat (Bac+8) à l'université
Il existe bien d'autres parcours possibles et de nombreuses combinaisons sont envisageables (BTS, puis une L3 professionnelle ; BUT, puis master...)
EXEMPLES de métiers après un bac STL Biotechnologie
-
Technicien·ne d'analyses de biologie médicale en laboratoire de ville ou à l'hôpital
-
Formulateur·trice en industrie cosmétique
-
Manipulateur·trice radio en radiologie et radiothérapie
-
Ingénieur·e agronome ou ingénieur·e agroalimentaire
-
Chercheur·euse
-
Et une multides d'autres métiers.... ! A toi de construire ton avenir !
Ci-dessus, une vidéo de présentation générale de la série STL (en haut), un exemple d'activité de microbiologie en laboratoire (au milieu), et les poursuites d'étude (en bas)



